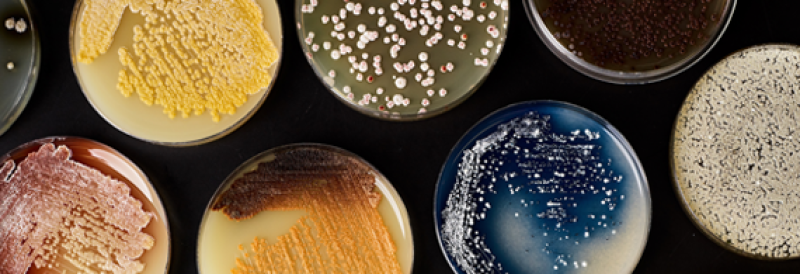
A multi-color collection of petri dishes with bacteria growing on them.

The U.S. National Science Foundation is an independent federal agency that supports science and engineering in all 50 states and U.S. territories.
NSF was established in 1950 by Congress to:
- Promote the progress of science.
- Advance the national health, prosperity and welfare.
- Secure the national defense.
We fulfill our mission chiefly by making grants. Our investments account for about 25% of federal support to America's colleges and universities for basic research: research driven by curiosity and discovery. We also support solutions-oriented research with the potential to produce advancements for the American people.
 On this page
On this page
In an average year, NSF:

Funds ~11,000 competitive awards for research, education and training

Supports ~1,900 colleges, universities and other institutions

Supports ~350,000 researchers, entrepreneurs, students and teachers
What we support
Discovery and innovation
NSF invests in researchers as they probe the unknown and seek to understand nature's great mysteries. These investments support basic research across all fields of fundamental science and engineering, except the medical sciences, as well as use-inspired research with the potential to create products and solutions that improve people's lives.
Partnerships
NSF supports research partnerships between colleges and universities, industry, nonprofits, government and other organizations within the U.S. and across the globe. These investments focus on sparking new ideas and creative approaches that can accelerate discovery and transform knowledge into tangible benefits to society.
Infrastructure
NSF invests in supercomputers, ground-based telescopes, research stations in the Arctic and Antarctic, the world's largest and highest-powered magnet lab, long-term ecological sites, engineering centers and other infrastructure and state-of-the-art tools to sustain the nation's scientific enterprise. Many of these facilities not only drive discoveries, but also serve as training grounds for the next generation of scientists and engineers.
Education
NSF invests in education and training programs that attract individuals from diverse backgrounds and from every sector. These investments — spanning pre-K through graduate school and beyond — ensure a pipeline of people and ideas ready to solve pressing global challenges in science and engineering.

Find funding
Search current funding opportunities from across NSF.
How we work
As described in our strategic plan, NSF is tasked with keeping the U.S. at the leading edge of discovery in science and engineering, to the benefit of all Americans.
NSF works closely with the research community to shape our numerous funding opportunities. Scientists, engineers and educators can join the agency as temporary program directors; these "rotators" make recommendations about which proposals to fund and influence new directions in the fields of science, engineering and education. We also support workshops and other events that help identify potentially transformative areas of inquiry for future funding.
NSF uses a rigorous system of merit review to ensure the proposals we receive are evaluated in a fair, competitive, transparent and in-depth manner. Each year, about 50,000 scientists, engineers and educators give their time to serve as independent reviewers of the proposals submitted to NSF.

Attend an NSF event
Join virtual information sessions for applicants, live chats with NSF researchers, exciting lectures from experts and more.
Who we are

Our leadership
Together, NSF's director and the National Science Board oversee the agency's long-range planning and activities.

How we're organized
NSF is organized into directorates and offices that support the various disciplines of science, engineering and education.

Our workforce
NSF's workforce is composed of federal employees as well as scientists from research institutions on a temporary basis.
Keep exploring
See recent news on NSF-supported discoveries that enrich knowledge and improve people's lives.
Invite NSF staff to speak to your classroom or group on a range of topics in science and engineering.
Explore NSF's investments in science and engineering across the nation and in your state.